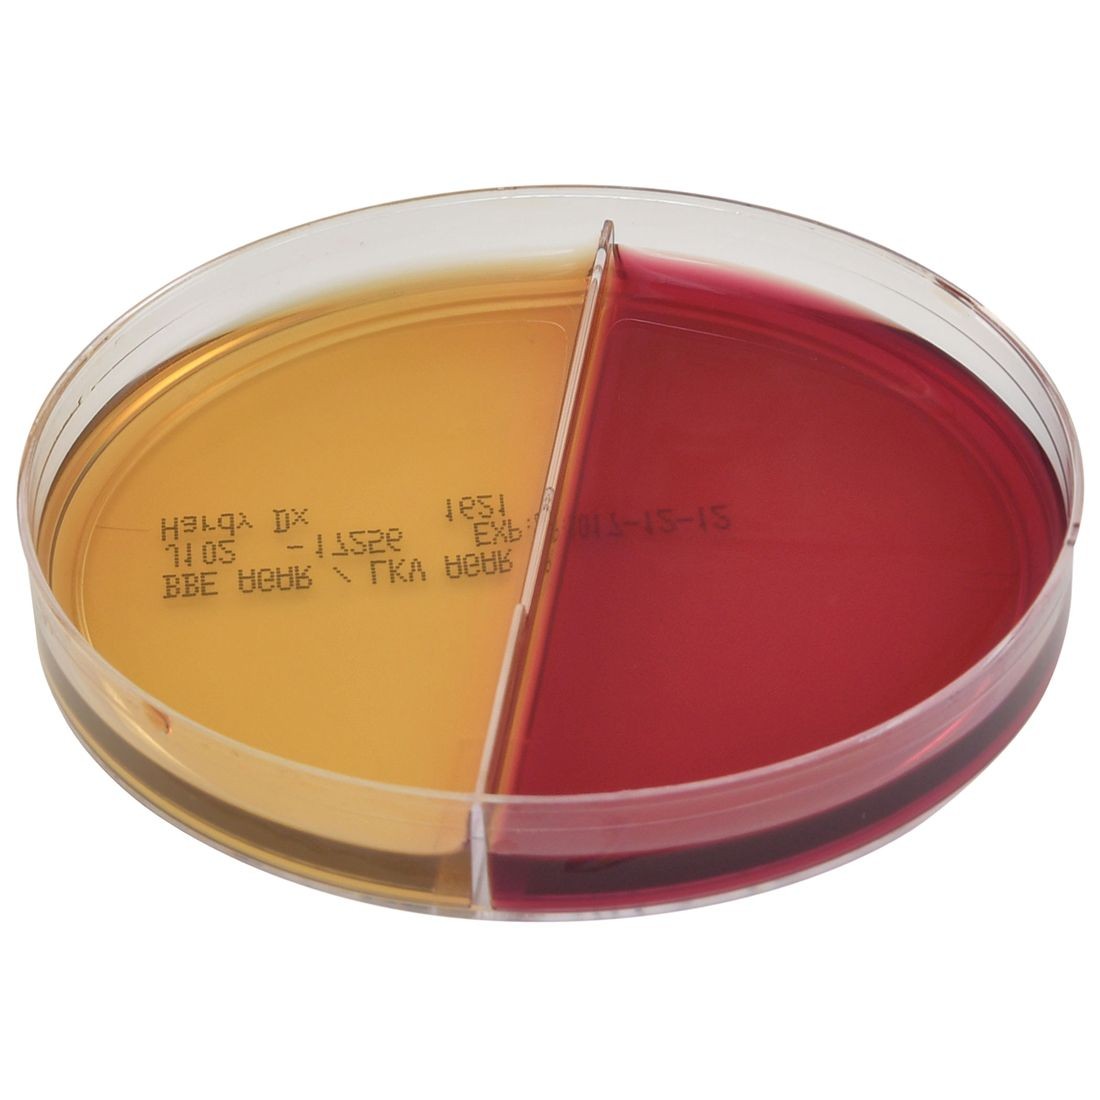
AnaeroGRO培养基

Hardy diagnostics
Hardy diagnostics成立于1980 年,总部位于美国,是一家微生物学诊断产品开发和生产的公司。Hardy diagnostics生产 2,700 多种产品,包括制备和脱水培养基、试剂、自动玻片过滤器以及快速鉴定试剂盒。目前Hardy diagnostics的培养基已经获得 FDA 许可和 ISO 13485 认证。
Hardy Diagnostics
Hardy Diagnostics 提供丰富的产品线,涵盖微生物培养基、诊断试剂、抗菌药物敏感性测试工具等。以下是其主要产品类别:
1. 微生物培养基:包括Tryptic Soy Agar (TSA)、Tryptic Soy Broth (TSB)、MacConkey Agar等,适用于细菌培养和分离。
2. 抗菌药物敏感性测试工具:如HardyDisk系列抗菌药物敏感性测试纸片。
3. 诊断试剂:如McFarland Latex Turbidity Standard,用于标准化细菌悬液的浓度。
4. 其他产品:包括稀释液、缓冲液、培养皿等。
微生物培养基:Hardy Diagnostics 提供一系列用于细菌和真菌培养的培养基,这些培养基设计用于支持特定微生物的生长,同时抑制其他微生物,以便进行准确的鉴定和计数。这些培养基可能包括显色培养基、选择性培养基和鉴别培养基。
特色产品:AnaeroGRO BBE/LKV,(拟杆菌胆汁七叶苷琼脂/湖羊血、卡那霉素和万古霉素),预还原培养基
拟杆菌胆汁蛋白琼脂是一种富集、选择性和差异性培养基,推荐用于快速分离和推定鉴定脆弱拟杆菌组嗜酸杆菌属的专性厌氧革兰氏阴性杆菌。
LKV(含卡那霉素和万古霉素的 Laked Blood)琼脂推荐用于选择性分离和部分鉴定专性厌氧革兰氏阴性杆菌,例如普雷沃氏菌属和拟杆菌属。
特点和优点:
• 预还原培养基包装在无氧充气铝箔袋中(含除氧剂袋、吸湿干燥剂包)
• 常温储存
• 提供多种包装组合:单板、双板和一级设置组合
• 经过验证的性能
• 在 FDA 许可的设施中制造
Hardy Diagnostics诊断试剂:Hardy Diagnostics生产用于感染性疾病诊断的试剂,支持快速和准确的病原体检测。
Hardy Diagnostics实验室耗材:Hardy Diagnostics提供实验室进行日常检测所需的各种耗材,如无菌拭子、培养皿、试剂管等,可以确保实验的无菌操作和结果的准确性。
Hardy Diagnostics实验室设备:Hardy Diagnostics提供一系列实验室设备,如恒温培养箱、生物安全柜、显微镜等。
Hardy Diagnostics食品安全检测:针对食品安全领域,Hardy Diagnostics提供检测食品中微生物污染的试剂和设备,包括用于检测沙门氏菌、大肠杆菌、李斯特菌等病原体的测试套件。
Hardy Diagnostics分子诊断产品:Hardy Diagnostics提供包括PCR试剂、核酸提取套件等,用于遗传和感染性疾病的分子水平诊断。
特色产品1. BB2827U134G箱 Tryptic Soy Broth (TSB) with Lecithin & Tween 80, USP, 90ml
• 产品名称:Tryptic Soy Broth (TSB) with Lecithin & Tween® 80
• 规格:90ml
• 产品描述: Tryptic Soy Broth 是一种使用较广的微生物培养基,添加卵磷脂(Lecithin)和吐温80(Tween 80)后,可增强培养基的稳定性和兼容性。该产品符合USP标准,适用于细菌增殖和培养。
• 应用领域:
o 细菌增殖和培养
o 微生物检测
o 药物敏感性测试
2. HWGZ9405VHD4 Eravacycline, 20μg, HDx, HardyDisk, 5x50disks
• 产品名称:Eravacycline, 20μg, HDx, HardyDisk
• 规格:5x50 disks
• 产品描述: Eravacycline 是一种新型抗菌药物,适用于抗菌药物敏感性测试。该产品以纸片形式提供,每盒包含5盒,每盒50片。HardyDisk系列纸片经过优化,确保测试结果的准确性和重复性。
• 应用领域:
o 抗菌药物敏感性测试
o 临床微生物学检测
o 研究用途


